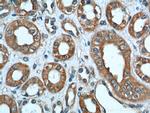
Polycystin 2 Antibody in Immunohistochemistry (Paraffin) (IHC (P))

Search
Proteintech
Polycystin 2 Polyclonal Antibody
{{$productOrderCtrl.translations['antibody.pdp.commerceCard.promotion.promotions']}}
{{$productOrderCtrl.translations['antibody.pdp.commerceCard.promotion.viewpromo']}}
{{$productOrderCtrl.translations['antibody.pdp.commerceCard.promotion.promocode']}}: {{promo.promoCode}} {{promo.promoTitle}} {{promo.promoDescription}}. {{$productOrderCtrl.translations['antibody.pdp.commerceCard.promotion.learnmore']}}
产品信息
19126-1-AP
种属反应
已发表种属
宿主/亚型
分类
类型
抗原
偶联物
形式
浓度
规格
纯化类型
保存液
内含物
保存条件
运输条件
靶标信息
Polycystin-2 (PC2), encoded by the PKD2 gene, is a multi-pass membrane protein that functions as a nonselective calcium-permeable cation channel, primarily localized to the primary cilium and endoplasmic reticulum. It plays a key role in calcium signaling and mechanosensation, often forming a complex with polycystin-1 to regulate cellular responses to fluid flow. Mutations in PKD2 disrupt these processes and lead to autosomal dominant polycystic kidney disease (ADPKD).
仅用于科研。不用于诊断过程。未经明确授权不得转售。
生物信息学
蛋白别名: autosomal dominant polycystic kidney disease type II; Autosomal dominant polycystic kidney disease type II protein; PC2; PKD2; polycystic kidney disease 2 (autosomal dominant); polycystic kidney disease 2 homolog; Polycystic kidney disease 2 protein; Polycystic kidney disease 2 protein homolog; polycystin 2; Polycystin-2; Polycystwin; R48321; Transient receptor potential cation channel subfamily P member 2; unnamed protein product
基因别名: APKD2; C030034P18Rik; Pc-2; PC2; PKD2; PKD4; RGD1559992; TRPP1; TRPP2
UniProt ID: (Human) Q13563, (Mouse) O35245
Entrez Gene ID: (Human) 5311, (Dog) 487852, (Rat) 498328, (Mouse) 18764